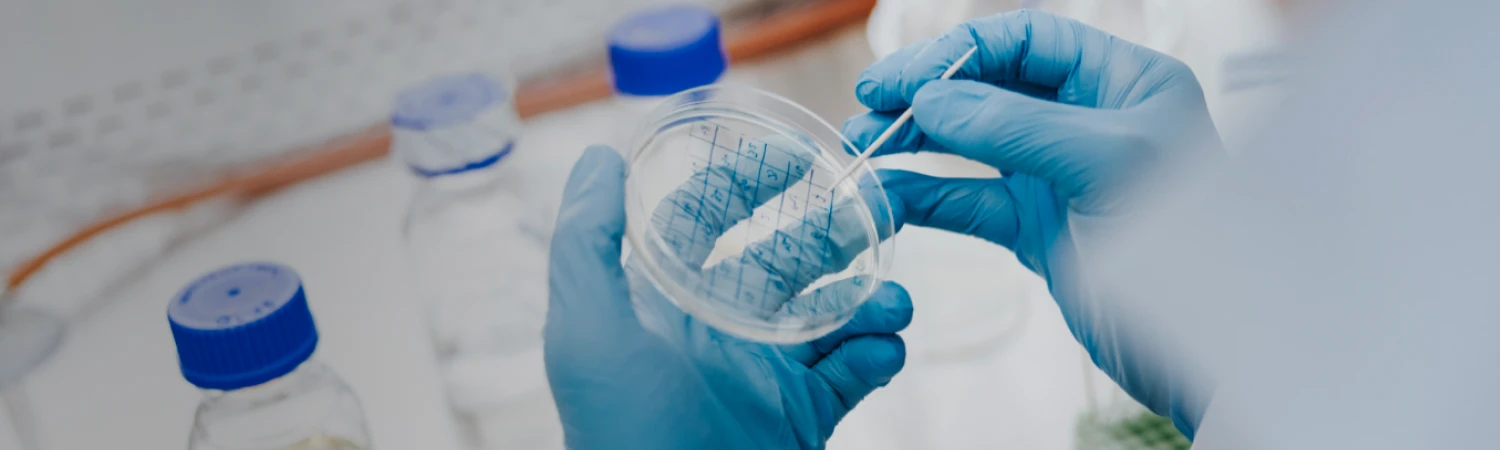
上毅生物科技股份有限公司

烯醇化酶-1 (enolase-1, ENO1),分子量47 kDa,通常位於細胞質中,主要功能為催化糖酵解途徑。值得注意的是,在病理情況下,例如發炎或是癌細胞轉移,ENO1會出現在細胞表面上,這個特性使ENO1成為獨特的抗體藥物標靶。當ENO1位於細胞表面上,有助於聚集循環中的纖溶酶原 (plasminogen),進一步產生纖溶酶 (plasmin)。纖溶酶是一種絲氨酸蛋白酶,能幫助發炎細胞或是癌細胞容易在組織間移動。所以透過ENO1抗體來阻斷纖溶酶產生,能有效抑制過度發炎反應或是癌轉移。
-

多發性硬化症
抗體藥物 HL247 -

多發性硬化症
抗體藥物 HL247 -

多發性硬化症
抗體藥物 HL247
HuL001為第一項研發而成
針對ENO1的抗體藥物
-
專利核心技術
上毅生技於2015年,自財團法人生物技術開發中心 (Development Center of Biotechnology, DCB) 及國家衛生研究院 (National Health Research Institutes, NHRI) 取得ENO1靶向技術專屬授權。針對ENO1在免疫疾病和癌症中扮演的重要角色,HuL001為第一項研發而成針對ENO1的抗體藥物,臨床前實驗結果顯示HuL001在多發性硬化症、類風溼性關節炎、肺纖維化、前列腺癌、多發性骨髓瘤等研究模式中,有相當好的療效。基於ENO1靶向技術 (原名:HuL001) 開發的抗體項目,目前正在進行各項臨床前試驗、毒理測試、藥理測試、以及藥物量產。
-
多發性硬化症抗體藥物 HL247
多發性硬化症 (multiple sclerosis, MS) 是一種神經脫髓鞘疾病,其中大腦和脊髓中神經細胞的絕緣層受損。這種損傷會破壞神經系統,導致身體和精神問題。目前的治療只能控制或減緩MS疾病進展,主要針對T、B淋巴細胞進行免疫調節。單核細胞浸潤到神經系統進行破壞,也是MS病理特色之一。基於ENO1有促進單核細胞浸潤之功能,利用HL247抗體藥物靶向抑制ENO1,在MS臨床前疾病模式中證明了HL247的療效。與目前的MS治療方法相比,HL247可能提供一種安全且新穎的治療方法。HL247用於MS之臨床研究藥物申請 (investigational new drug, IND) 已於2019年被美國食品藥物管理局 (food and drug administration, FDA) 批准。
-
特發性肺纖維化抗體藥物 HL217
特發性肺纖維化 (idiopathic pulmonary fibrosis, IPF) 是一種原因不明的破壞性肺病,其特徵是肺部瘢痕或纖維化組織的積累。患者會出現呼吸困難,診斷後的中位生存期僅有3~5 年。從2014年至今只有兩種藥物獲批,nintedanib (抑肺纖Ofev®) 和 pirfenidone (比樂舒活Esbriet®),可幫助減緩IPF患者肺功能衰退,但不能完全治癒,替代療法的需求仍然很大。HL217的治療功效在臨床前研究模型中已得到證實,並在台灣已通過衛福部食品藥物管理署 (Taiwan Food and Drug Administration, TFDA) 批准用於IPF之臨床試驗 (ClinicalTrials.gov Identifier: NCT04540770)。在健康志願者中進行的臨床一期研究,結果顯示良好的安全性和耐受性。
-
癌症藥物 HL227
大量文獻指出ENO1在各類癌症中過度表達,與較差的臨床預後相關。ENO1抗體在多種癌症研究模型中也展現抗癌效果,例如胰腺癌 (PMID: 25860938)、肺癌 (PMID: 23894455, 33579362, and 34145039) 和子宮頸癌 (PMID: 34094663)。上毅生技專利ENO1抗體HL227之抗癌效果,也在晚期前列腺癌研究模式中得到證實,其獨特的機轉不僅針對癌細胞本身,且針對腫瘤微環境中病態細胞進行抑制。HL227可緩解腫瘤生長、血管生成、細胞遷移、細胞因子分泌、破骨細胞生成,證明HL227多面向治療功效。研究成果已刊登於國際研究期刊 (PMID: 35700013;環球生技報導)。
HL227目前正在多發性骨髓瘤研究模式中進行測試。在大腸癌研究模式中也發現HL227與放射線治療合併使用,可更有效抑制腫瘤生長。研究成果已刊登於國際研究期刊(DOI: 10.3892/or.2023.8642),可望與現行的多發性骨髓瘤治療方法合併使用,提供病人更多的選。









